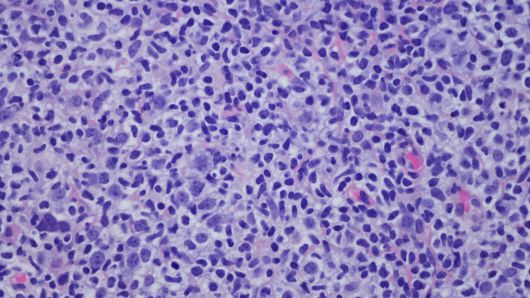

癌症“疫苗”也许不再是梦想,研究获得初步成功或可治愈癌症快报
纽约西奈山医院的研究人员对11名淋巴瘤患者进行了治疗测试,研究人员直接在肿瘤内部进行治疗,研究人员数十年来一直在尝试制造癌症疫苗。
北京时间4月9日消息,根据近日发表在《自然医学》杂志上的一项研究,一种实验性癌症“疫苗”在一项针对淋巴瘤患者的小规模临床试验中获得初步成功。纽约西奈山医院的研究人员对11名淋巴瘤患者进行了治疗测试,并获得成功。这以测试结果又从侧面证明了此前三月份对淋巴瘤患者以及乳腺癌和头颈癌进行另一项临床试验。
据研究人员透露,在最初的人体试验中,部分患者的病情在数月甚至数年内得到完全控制。该研究的主要作者、淋巴瘤免疫治疗项目主任乔舒亚·布罗迪(Joshua Brody)博士表示,这种疗法“对多种癌症有广泛的意义,并能够增加其他免疫治疗的成功率,如检查点阻断。”
研究人员将这种疗法称之为“疫苗”,虽然不具备流感疫苗这样的预防作用,但它能使人的免疫系统对抗疾病,并教会身体识别攻击肿瘤。研究人员直接在肿瘤内部进行治疗。他们给肿瘤注射一种刺激物来募集免疫细胞,用低剂量的放射治疗肿瘤,然后注射一种刺激物来激活免疫细胞。被激活的免疫细胞随后在全身传播并杀死肿瘤。
研究发现,在接受测试的三名患者中,该疗法不仅对针对治疗肿瘤有效,对其他肿瘤也有一定效果,患者的病情得到控制。韦尔康奈尔医学院和纽约长老会放射肿瘤学主席席尔维亚·福门蒂博士直言“该疗法非常有前途,这并不仅仅表现在所治疗的领域,对于放射治疗之外的领域也非常重要。”
不过,由于仅在三位患者身上出现效果,因此有专家指出,这一研究结果属于概念上的证明,尽管研究结果令人兴奋,但还需要进行更多大量的研究。
实际上,研究人员数十年来一直在尝试制造癌症疫苗,但未能成功。免疫疗法的新研究重新激发了他们的努力。这种“疫苗”激活了树突状细胞,树突状细胞负责启动免疫反应,这些细胞随后指示T细胞对患者体内肿瘤展开攻击。
1.TMT观察网遵循行业规范,任何转载的稿件都会明确标注作者和来源;
2.TMT观察网的原创文章,请转载时务必注明文章作者和"来源:TMT观察网",不尊重原创的行为TMT观察网或将追究责任;
3.作者投稿可能会经TMT观察网编辑修改或补充。

